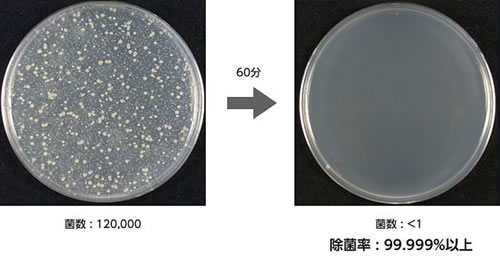
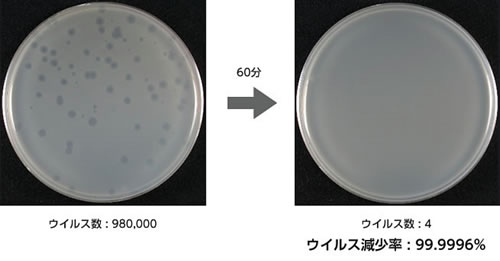

|
|
■包装資材 ■包装機械 ■物流機器 ■測定機器 ■洗剤 ■ケミカル ■蛍光灯 ■季節品-夏 ■季節品-冬 ■弱電工具 ■ホイスト ■環境機器 ■掃除機 ■ムーブテック ■切削工具 ■機械工具■調理厨房機器 ■研究室用品 ■安全防犯防災品 ■エクステリア ■新商品 ■在庫処分

|
光触媒式脱臭除菌空気清浄器/品番 M812PC-F10K
|
【詳細表示】 | |||||||||||||||||||||||||||||||||||||||||||||||||||||||||||||||||||||||||
| 商品番号 | M812PC-F10K | 価 格 | ||||||||||||||||||||||||||||||||||||||||||||||||||||||||||||||||||||||||
 |
高性能光触媒フィルタにより悪臭物質・VOC等を分解脱臭し、またウイルス等を不活化し除菌します。 イオナイザも内蔵している低ランニングコストの脱臭・除菌装置です。 |
光触媒式脱臭除菌空気清浄器 品番 M812PC-F10K 廃番 |
||||||||||||||||||||||||||||||||||||||||||||||||||||||||||||||||||||||||
| ■概要 高性能3次元Si/Sic光触媒フィルタにより、有人空間を安全・確実に除菌・脱臭する装置です。 アンモニアやホルムアルデヒトなど空気中の悪臭物質やVOC等の化学物質を分解脱臭し、また室内の浮遊菌やウイルスを取り込んで光触媒の働きにより不活化し除菌します。 長寿命部品を採用しているため、長期に渡り部品交換などの費用も発生せず、低ランニングコストなのも特長です。 病院・介護施設・幼保育園・研究施設・ホテルなどの除菌・脱臭に最適です。 ■特徴 ●脱臭機能 アンモニアやホルムアルデヒドなど、空気中の悪臭物質やVOC等の化学物質を光触媒で分解・脱臭します ●除菌機能 室内の浮遊菌やウイルスを取り込んで、光触媒の働きにより不活化します ●高性能フィルタ 3次元Si/SiC光触媒フィルタを採用し、高効率・大風量を実現しました ●優れたメンテナンス 長寿命部品を採用しているため、長期に渡り部品交換等の費用が発生しません (1次・2次フィルタは水洗いして繰り返し使用できますが、破損したり汚れがひどくなった場合は交換が必要となります。 ※消耗品扱い) ●イオン効果 内蔵のイオナイザにより、壁などの除菌・防カビなどにも効果を発揮します(M812PC-F10Kのみ) ■タイプ
■光触媒の効果. 空気中の水分からOHラジカル等を発生させ、菌や悪臭成分を酸化分解します。   ■ガス分解性能試験結果 (メーカー試験)   ■除菌性能試験結果(公的機関による試験) 試験菌:黄色ブドウ球菌 試験機関:財団法人 北里環境科学センター 試験No. :北生発23_0230号 試験品名:M812PC-F10K 試験方法:1m3空間内で菌噴霧後、60分運転 ■ウイルス除去性能試験結果(公的機関による試験) 試験ウイルス:大腸菌ファージ(インフルエンザ代替) 試験機関:財団法人 北里環境科学センター 試験No. :北生発23_0295号 試験品名:M812PC-F10K 試験方法:1m3空間内でウイルス噴霧後、60分運転 ■用途 ●介護施設 居室・トイレ・汚物処理室など、気になるニオイの脱臭とともに除菌により清潔な環境に ●動物病院・ペットショップ 動物臭・し尿臭の低減、毛や浮遊菌などの除去による、クリーンな空間の提供 ●病院・研究施設 細菌・真菌・ウイルス抑制による院内感染対策やホルマリンなど薬品臭の分解・脱臭に ●オフィス・学校施設 VOC分解によるシックハウス対策、花粉除去や除菌・脱臭による快適で安全な環境の実現 ●食品加工工場・飲食店 浮遊菌・カビの除去による衛生対策やエチレンガス分解による食材の鮮度保持に ■構造 空孔率96%の特殊セラミックフィルタで、効率の良い除菌・脱臭・VOC分解が可能に ※イオナイザ、1次フィルタ、リモコンはM812PC-F10Kのみにある機能です  ■仕様
■消耗品・オプション
|
||||||||||||||||||||||||||||||||||||||||||||||||||||||||||||||||||||||||||
運賃、および消費税は、記載価格には、含まれていません。

[トップページに戻る] [注文書] [見積り依頼] TEL 0729-64-8663 FAX 0729-61-4874
営業時間 AM9:00~PM7:00 営業日 月曜日~金曜日 定休日 土曜日 日曜日 祝日